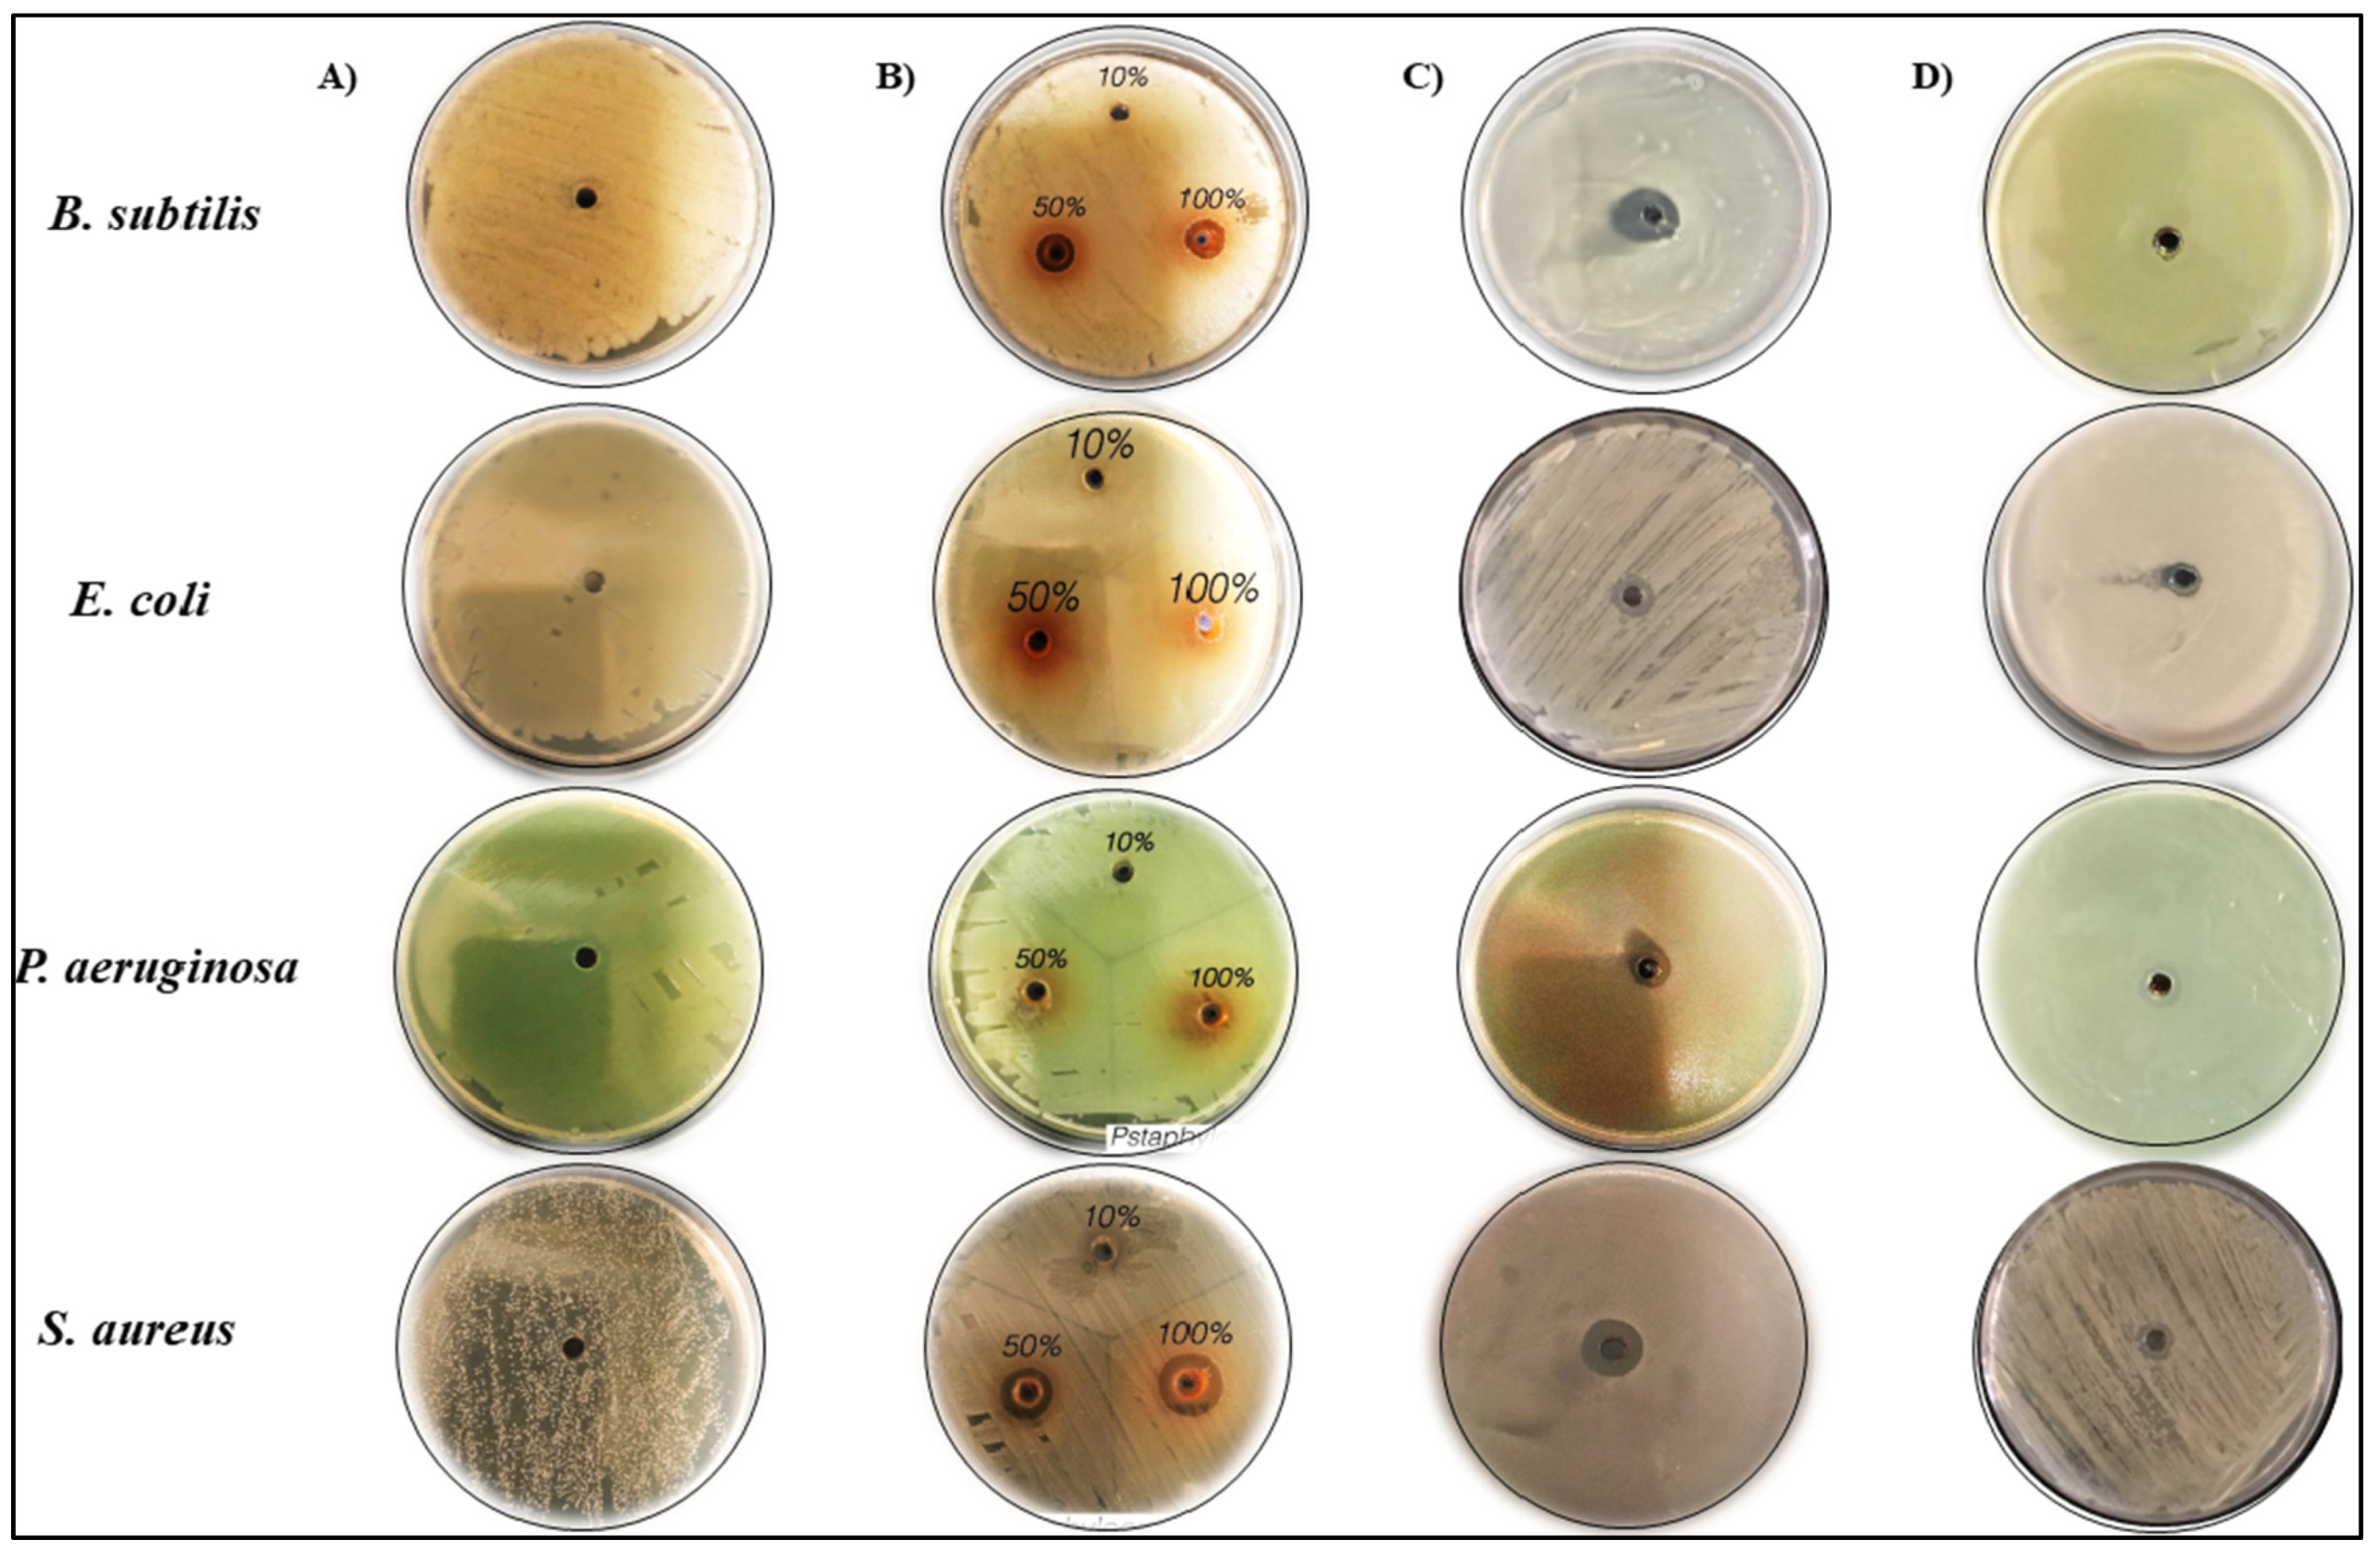
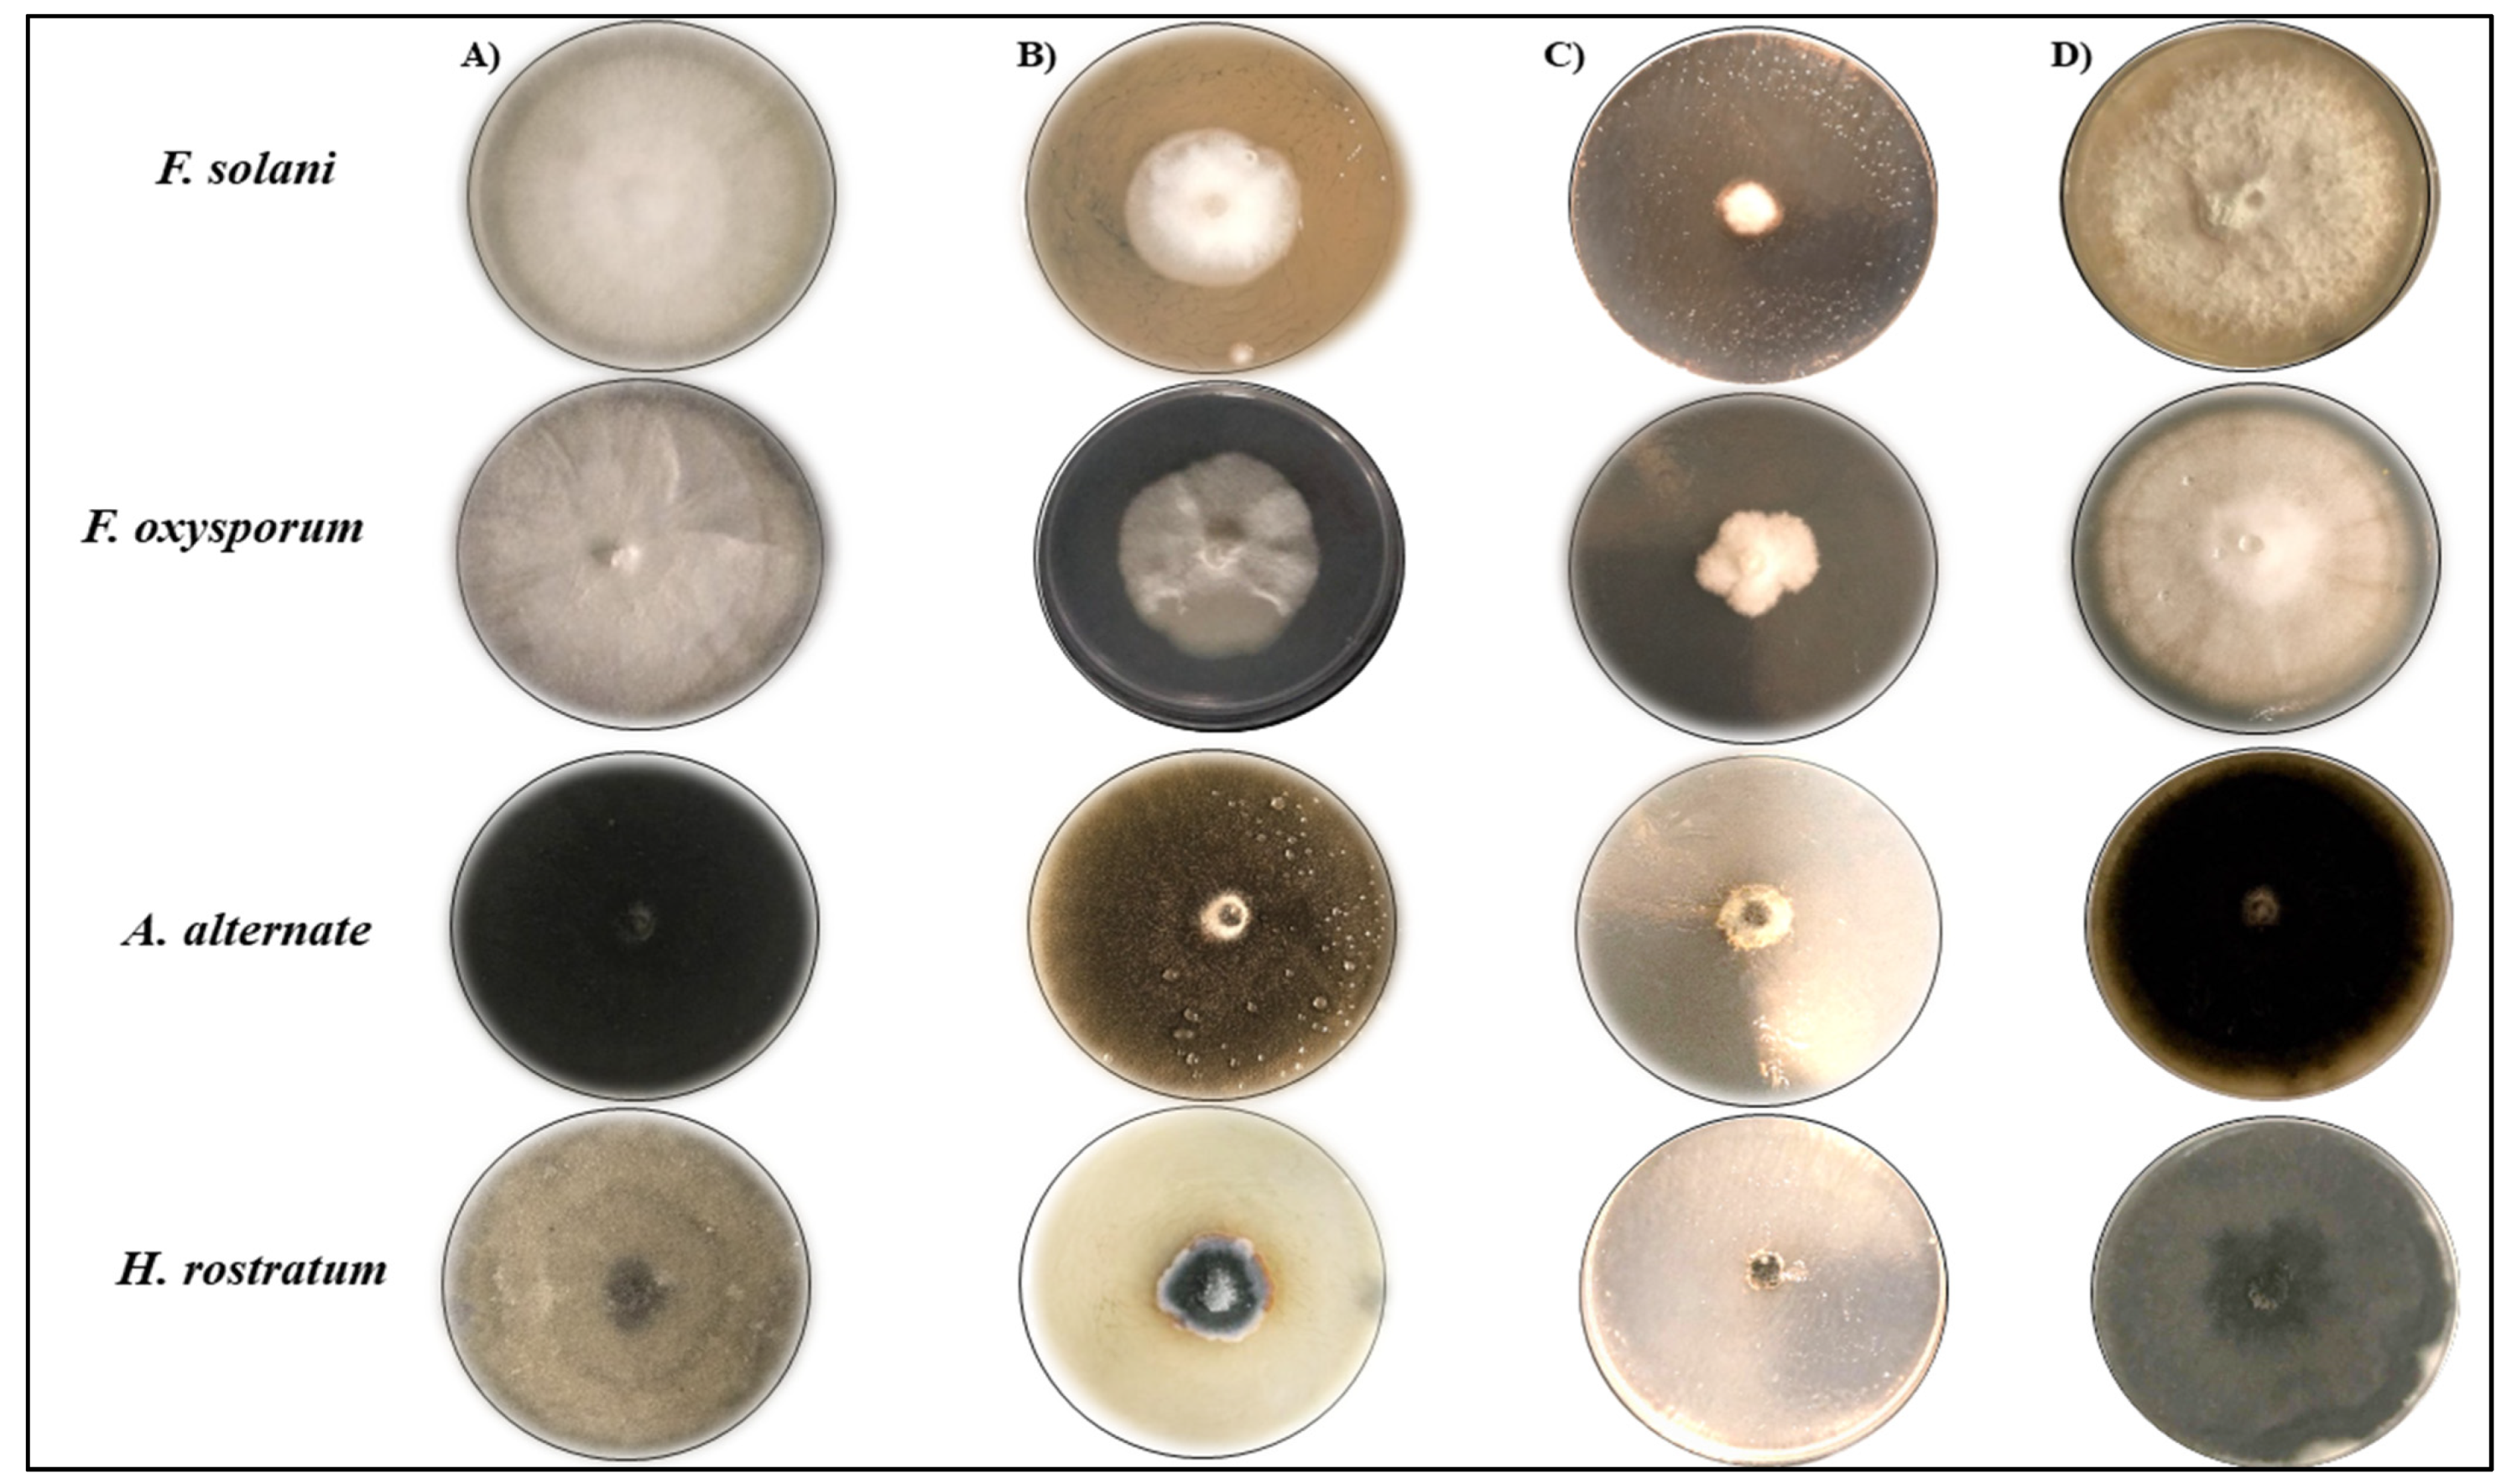

The Antimicrobial Activities of Silver Nanoparticles from Aqueous Extract of Grape Seeds against Pathogenic Bacteria and Fungi
Abstract
1. Introduction
2. Results and Discussion
2.1. The Morphological Characteristics the Biosynthesized GSE-AgNPs
2.2. The Chemical Composition Analysis of the Studied Materials
2.3. Antibacterial Activity of GSE and the Biosynthesis of GSE-AgNPs
2.4. Antifungal Activity of GSE and the Biosynthesis of GSE-AgNPs
3. Materials and Methods
3.1. Chemicals and Reagents
3.2. Preparation of Aqueous GSE
3.3. Microorganisms
3.4. Bio Synthesis of Silver Nanoparticles of GSE
3.5. Characterization of Synthesized GSE-AgNPs
3.5.1. UV Spectroscopy
3.5.2. Dynamic Light Scattering (DLS) Analysis
3.5.3. Field Emission Scanning Electron Microscopy (FE-SEM)
3.5.4. Transmission Electron Microscopy (TEM)
3.5.5. Fourier-Transform Infrared Spectroscopy (FTIR)
3.5.6. Gas Chromatography/Mass Spectrometry Technique (GC/MS)
3.6. Determination Antimicrobial Activity
3.6.1. Determination of Antibacterial Activity
3.6.2. Determination of Antifungal Activity
3.7. Statistical Analysis
4. Conclusions
Author Contributions
Funding
Institutional Review Board Statement
Informed Consent Statement
Data Availability Statement
Acknowledgments
Conflicts of Interest
Sample Availability
References
- Hintz, T.; Matthews, K.K.; Di, R. The Use of Plant Antimicrobial Compounds for Food Preservation. Biomed Res. Int. 2015, 2015, 246264. [Google Scholar] [CrossRef]
- Hashempour-Baltork, F.; Hosseini, H.; Shojaee-Aliabadi, S.; Torbati, M.; Alizadeh, A.M.; Alizadeh, M. Drug Resistance and the Prevention Strategies in Food Borne Bacteria: An Update Review. Adv. Pharm. Bull. 2019, 9, 335–347. [Google Scholar] [CrossRef] [PubMed]
- Othman, L.; Sleiman, A.; Abdel-Massih, R.M. Antimicrobial Activity of Polyphenols and Alkaloids in Middle Eastern Plants. Front. Microbiol. 2019, 10, 911. [Google Scholar] [CrossRef] [PubMed]
- Memar, M.Y.; Adibkia, K.; Farajnia, S.; Kafil, H.S.; Yekani, M.; Alizadeh, N.; Ghotaslou, R. The grape seed extract: A natural antimicrobial agent against different pathogens. Rev. Med. Microbiol. 2019, 30, 173–182. [Google Scholar] [CrossRef]
- Perumalla, A.V.S.; Hettiarachchy, N.S. Green tea and grape seed extracts—Potential applications in food safety and quality. Food Res. Int. 2011, 44, 827–839. [Google Scholar] [CrossRef]
- Mahmoud, Y.I. Grape seed extract neutralizes the effects of Cerastes cerastes cerastes post-synaptic neurotoxin in mouse diaphragm. Micron 2013, 44, 298–302. [Google Scholar] [CrossRef]
- GRAS Notice 658, Grapefruit Extract—FDA: Notice to the US Food and Drug Administration That the Use of Vancitrix™, a Glycerin Citrus Extract, Is Generally Recognized as Safe. Available online: https://www.fda.gov/food/generally-recognized-safe-gras/gras-notice-inventory (accessed on 25 August 2021).
- Ramazanzadeh, B.; Jahanbin, A.; Yaghoubi, M.; Shahtahmassbi, N.; Ghazvini, K.; Shakeri, M.; Shafaee, H. Comparison of Antibacterial Effects of ZnO and CuO Nanoparticles Coated Brackets against Streptococcus Mutans. J. Dent. 2015, 16, 200–205. [Google Scholar]
- Wang, L.; Hu, C.; Shao, L. The antimicrobial activity of nanoparticles: Present situation and prospects for the future. Int. J. Nanomed. 2017, 12, 1227–1249. [Google Scholar] [CrossRef] [PubMed]
- Kuppusamy, P.; Yusoff, M.M.; Maniam, G.P.; Govindan, N. Biosynthesis of metallic nanoparticles using plant derivatives and their new avenues in pharmacological applications—An updated report. Saudi Pharm. J. 2016, 24, 473–484. [Google Scholar] [CrossRef]
- Xu, H.; Wang, L.; Su, H.; Gu, L.; Han, T.; Meng, F.; Liu, C. Making Good Use of Food Wastes: Green Synthesis of Highly Stabilized Silver Nanoparticles from Grape Seed Extract and Their Antimicrobial Activity. Food Biophys. 2015, 10, 12–18. [Google Scholar] [CrossRef]
- Ji, J.H.; Jung, J.H.; Yu, I.J.; Kim, S.S. Long-term stability characteristics of metal nanoparticle generator using small ceramic heater for inhalation toxicity studies. Inhal. Toxicol. 2007, 19, 745–751. [Google Scholar] [CrossRef]
- Iravani, S.; Korbekandi, H.; Mirmohammadi, S.V.; Zolfaghari, B. Synthesis of silver nanoparticles: Chemical, physical and biological methods. Res. Pharm. Sci. 2014, 9, 385–406. [Google Scholar]
- Shi, J.; Yu, J.; Pohorly, J.E.; Kakuda, Y. Polyphenolics in grape seeds-biochemistry and functionality. J. Med. Food 2003, 6, 291–299. [Google Scholar] [CrossRef]
- Zhang, X.F.; Liu, Z.G.; Shen, W.; Gurunathan, S. Silver Nanoparticles: Synthesis, Characterization, Properties, Applications, and Therapeutic Approaches. Int. J. Mol. Sci. 2016, 17, 1534. [Google Scholar] [CrossRef]
- François, E.M.; Marcelle, L.S.; Cecile, O.E.; Agnes, A.N.; Djiopang, Y.S.; Fanny, A.E.M.; Lidwine, N.; Harouna, M.; Emmanuel, M.M. Unexplored vegetal green synthesis of silver nanoparticles: A preliminary study with Corchorus olitorus Linn and Ipomea batatas (L.) Lam. Afr. J. Biotechnol. 2016, 15, 341–349. [Google Scholar] [CrossRef]
- Roy, K.; Biswas, S.; Banerjee, P.C. Synthesis of Silver Nanoparticles by Using Grape (Vitis vinifera) Fruit Extract: Characterization of the Particles and Study of Antibacterial Activity. Res. J. Pharm. Biol. Chem. Sci. 2013, 4, 1271–1278. [Google Scholar] [CrossRef]
- Bastos-Arrieta, J.; Florido, A.; Pérez-Ràfols, C.; Serrano, N.; Fiol, N.; Poch, J.; Villaescusa, I. Green Synthesis of Ag Nanoparticles Using Grape Stalk Waste Extract for the Modification of Screen-Printed Electrodes. Nanomaterials 2018, 8, 946. [Google Scholar] [CrossRef] [PubMed]
- Shejawal, K.P.; Randive, D.S.; Bhinge, S.D.; Bhutkar, M.A.; Wadkar, G.H.; Jadhav, N.R. Green synthesis of silver and iron nanoparticles of isolated proanthocyanidin: Its characterization, antioxidant, antimicrobial, and cytotoxic activities against COLO320DM and HT29. J. Genet. Eng. Biotechnol. 2020, 18, 43. [Google Scholar] [CrossRef] [PubMed]
- Loureiro, J.A.; Andrade, S.; Duarte, A.; Neves, A.R.; Queiroz, J.F.; Nunes, C.; Sevin, E.; Fenart, L.; Gosselet, F.; Coelho, M.A.; et al. Resveratrol and Grape Extract-loaded Solid Lipid Nanoparticles for the Treatment of Alzheimer’s Disease. Molecules 2017, 22, 277. [Google Scholar] [CrossRef]
- Castellani, S.; Trapani, A.; Spagnoletta, A.; di Toma, L.; Magrone, T.; Di Gioia, S.; Mandracchia, D.; Trapani, G.; Jirillo, E.; Conese, M. Nanoparticle delivery of grape seed-derived proanthocyanidins to airway epithelial cells dampens oxidative stress and inflammation. J. Transl. Med. 2018, 16, 140. [Google Scholar] [CrossRef]
- Brodusch, N.; Brahimi, S.V.; Barbosa De Melo, E.; Song, J.; Yue, S.; Piché, N.; Gauvin, R. Scanning Electron Microscopy versus Transmission Electron Microscopy for Material Characterization: A Comparative Study on High-Strength Steels. Scanning 2021, 2021, 5511618. [Google Scholar] [CrossRef]
- Hadjiivanov, K. Chapter Two—Identification and Characterization of Surface Hydroxyl Groups by Infrared Spectroscopy. In Advances in Catalysis; Jentoft, F.C., Ed.; Academic Press: Cambridge, MA, USA, 2014; Volume 57, pp. 99–318. [Google Scholar] [CrossRef]
- Mohansrinivasan, V.; Devi, S.C.; Meenakshi, D.; Biswas, A.; Naine, J. Exploring the Anticancer Activity of Grape Seed Extract on Skin Cancer Cell Lines A431. Braz. Arch. Biol. Technol. 2015, 58, 540–546. [Google Scholar] [CrossRef]
- Naik, K.K.; Thangavel, S.; Alam, A.; Kumar, S. Flavone Analogues as Antimicrobial Agents. Recent Pat. Inflamm. Allergy Drug Discov. 2017, 11, 53–63. [Google Scholar] [CrossRef]
- Salamon, I.; Şimşek Sezer, E.N.; Kryvtsova, M.; Labun, P. Antiproliferative and Antimicrobial Activity of Anthocyanins from Berry Fruits after Their Isolation and Freeze-Drying. Appl. Sci. 2021, 11, 2096. [Google Scholar] [CrossRef]
- Mahmad, N.; Taha, R.M.; Othman, R.; Abdullah, S.; Anuar, N.; Elias, H.; Rawi, N. Anthocyanin as potential source for antimicrobial activity in Clitoria ternatea L. and Dioscorea alata L. Pigment Resin Technol. 2018, 47, 490–495. [Google Scholar] [CrossRef]
- Li, Y.; Xia, H.; Wu, M.; Wang, J.; Lu, X.; Wei, S.; Li, K.; Wang, L.; Wang, R.; Zhao, P.; et al. Evaluation of the Antibacterial Effects of Flavonoid Combination from the Leaves of Dracontomelon dao by Microcalorimetry and the Quadratic Rotary Combination Design. Front. Pharmacol. 2017, 8, 70. [Google Scholar] [CrossRef] [PubMed]
- Gorodyska, O.; Grevtseva, N.; Samokhvalova, O.; Gubsky, S. Determination of the cemical composition of grape seed powders by GC-MS analysis. EUREKA Life Sci. 2018, 6, 3–8. [Google Scholar] [CrossRef]
- Aybastıer, Ö.; Dawbaa, S.; Demir, C. Investigation of antioxidant ability of grape seeds extract to prevent oxidatively induced DNA damage by gas chromatography-tandem mass spectrometry. J. Chromatogr. B 2018, 1072, 328–335. [Google Scholar] [CrossRef] [PubMed]
- Lin, L.Z.; Sun, J.; Chen, P.; Monagas, M.J.; Harnly, J.M. UHPLC-PDA-ESI/HRMSn profiling method to identify and quantify oligomeric proanthocyanidins in plant products. J. Agric. Food Chem. 2014, 62, 9387–9400. [Google Scholar] [CrossRef] [PubMed]
- Silvan, J.M.; Mingo, E.; Hidalgo, M.; de Pascual-Teresa, S.; Carrascosa, A.; Martínez-Rodríguez, A. Antibacterial activity of a grape seed extract and its fractions against Campylobacter spp. Food Control 2013, 29, 25–31. [Google Scholar] [CrossRef]
- Molva, E.; Baysal, A.H. Antimicrobial activity of grape seed extract on Alicyclobacillus acidoterrestris DSM 3922 vegetative cells and spores in apple juice. LWT Food Sci. Technol. 2015, 60, 238–245. [Google Scholar] [CrossRef]
- Alkhulaifi, M.; Alfarraj, D.; Moubayed, N. In vitro Antibacterial Activity of Red Grape Seed Extracts on some Important Human Pathogenic Bacteria. J. Adv. Microbiol. 2017, 3, 78–84. [Google Scholar] [CrossRef]
- Baydar, N.G.; Özkan, G.; Sağdiç, O. Total phenolic contents and antibacterial activities of grape (Vitis vinifera L.) extracts. Food Control 2004, 15, 335–339. [Google Scholar] [CrossRef]
- Han, H.W.; Kwak, J.H.; Jang, T.S.; Knowles, J.C.; Kim, H.W.; Lee, H.H.; Lee, J.H. Grapefruit Seed Extract as a Natural Derived Antibacterial Substance against Multidrug-Resistant Bacteria. Antibiotics 2021, 10, 85. [Google Scholar] [CrossRef]
- Asaduzzaman, A.K.M.; Chun, B.; Kabir, S.R. Vitis vinifera Assisted Silver Nanoparticles with Antibacterial and Antiproliferative Activity against Ehrlich Ascites Carcinoma Cells. J. Nanopart. 2016, 2016, 1–9. [Google Scholar] [CrossRef]
- Ramesh, G.; Joshi, P.S.; Packiyam, J.M.; Jayanna, S.K. Biosynthesis and characterization of Silver Nanoparticles from Grape (Vitis vinifera) seeds and study on antibacterial activity. Int. J. Curr. Res. Chem. Pharm. Sci. 2017, 4, 5–11. [Google Scholar] [CrossRef]
- Shrestha, B.; Theerathavaj, M.L.; Thaweboon, S.; Thaweboon, B. In vitro antimicrobial effects of grape seed extract on peri-implantitis microflora in craniofacial implants. Asian Pac. J. Trop. Biomed. 2012, 2, 822–825. [Google Scholar] [CrossRef]
- Matsumura, Y.; Yoshikata, K.; Kunisaki, S.; Tsuchido, T. Mode of bactericidal action of silver zeolite and its comparison with that of silver nitrate. Appl. Environ. Microbiol. 2003, 69, 4278–4281. [Google Scholar] [CrossRef] [PubMed]
- Kumar Pandian, S.R.; Deepak, V.; Kalishwaralal, K.; Viswanathan, P.; Gurunathan, S. Mechanism of bactericidal activity of silver nitrate—A concentration dependent bi-functional molecule. Braz. J. Microbiol. 2010, 41, 805–809. [Google Scholar] [CrossRef]
- Eslami, H.; Babaei, H.; Mehrbani, S.P.; Aghazadeh, M.; Babaei, Z.; Nezhad, S.K. Evaluation of antifungal effect of grape seed extract (GSE) on Candida glabrata and Candida krusei: In vitro study. Biomed. Res. 2017, 28, 9163–9170. [Google Scholar]
- Simonetti, G.; Santamaria, A.R.; D’Auria, F.D.; Mulinacci, N.; Innocenti, M.; Cecchini, F.; Pericolini, E.; Gabrielli, E.; Panella, S.; Antonacci, D.; et al. Evaluation of Anti-Candida Activity of Vitis vinifera L. Seed Extracts Obtained from Wine and Table Cultivars. BioMed Res. Inter. 2014, 2014, 1–11. [Google Scholar] [CrossRef]
- Fraternale, D.; Ricci, D.; Verardo, G.; Gorassini, A.; Stocchi, V.; Sestili, P. Activity of Vitis vinifera tendrils extract against phytopathogenic fungi. Nat. Prod. Commun. 2015, 10, 1037–1042. [Google Scholar] [CrossRef]
- Nechita, A.; Filimon, R.V.; Filimon, R.M.; Colibaba, L.-C.; Gherghel, D.; Damian, D.; Pașa, R.; Cotea, V.V. In vitro Antifungal Activity of a New Bioproduct Obtained from Grape Seed Proanthocyanidins on Botrytis cinerea Mycelium and Spores. Not. Bot. Horti Agrobot. Cluj Napoca 2018, 47, 418–425. [Google Scholar] [CrossRef][Green Version]
- Baykan, M.; Doğan, M.; Ege, D.; Kara, Z. Effectiveness of Grape (Vitis Vinifera, L.) Seed Extracts on Fungi and Bacteria Management. Selcuk J. Agric. Food Sci. 2018, 32, 366–372. [Google Scholar] [CrossRef]
- Sagana, M.; Rajasekar, A.; Rajeshkumar, S. Antifungal Activity of Grape Seed Extract Mediated Zinc Oxide Nanoparticles—An In Vitro Study. Plant. Cell Biotechnol. Mol. Biol. 2020, 21, 14–20. Available online: https://www.ikprress.org/index.php/PCBMB/article/view/5333 (accessed on 30 July 2021).
- Shivani, N.; Rajasekar, A.; Rajeshkumar, S. Antifungal Activity of Grape Seed Extract Mediated Titanium Oxide Nanoparticles against Candida Albicans: An In Vitro Study. Plant. Cell Biotechnol. Mol. Biol. 2020, 21, 8–15. Available online: Https://Ikpresse.Com/Index.Php/Pcbmb/Article/View/5379 (accessed on 30 July 2021).
- Pingale, S.S.; Rupanar, S.V.; Chaskar, M.G. Plant- mediated biosynthesis of silver nanoparticles from Gymnema sylvestre and their use in phtodegradation of Methyl orange dye. J. Water Environ. Nanotechnol. 2018, 3, 106–115. [Google Scholar] [CrossRef]
- Bhattacharjee, S. DLS and zeta potential—What they are and what they are not? J. Control. Release 2016, 235, 337–351. [Google Scholar] [CrossRef]
- Stetefeld, J.; McKenna, S.A.; Patel, T.R. Dynamic light scattering: A practical guide and applications in biomedical sciences. Biophys. Rev. 2016, 8, 409–427. [Google Scholar] [CrossRef] [PubMed]
- Al-Otibi, F.; Al-Ahaidib, R.A.; Alharbi, R.I.; Al-Otaibi, R.M.; Albasher, G. Antimicrobial Potential of Biosynthesized Silver Nanoparticles by Aaronsohnia factorovskyi Extract. Molecules 2020, 26, 130. [Google Scholar] [CrossRef]
- Alotibi, F.O.; Ashour, E.H.; Al-Basher, G. Evaluation of the antifungal activity of Rumex vesicarius L. and Ziziphus spina-christi (L.) Desf. Aqueous extracts and assessment of the morphological changes induced to certain myco-phytopathogens. Saudi J. Biol. Sci. 2020, 27, 2818–2828. [Google Scholar] [CrossRef]
- Valand, R.; Tanna, S.; Lawson, G.; Bengtström, L. A review of Fourier Transform Infrared (FTIR) spectroscopy used in food adulteration and authenticity investigations. Food Addit. Contam. Part A 2020, 37, 19–38. [Google Scholar] [CrossRef] [PubMed]
- Balouiri, M.; Sadiki, M.; Ibnsouda, S.K. Methods for in vitro evaluating antimicrobial activity: A review. J. Pharm. Anal. 2016, 6, 71–79. [Google Scholar] [CrossRef] [PubMed]
- Javan Bakht Dalir, S.; Djahaniani, H.; Nabati, F.; Hekmati, M. Characterization and the evaluation of antimicrobial activities of silver nanoparticles biosynthesized from Carya illinoinensis leaf extract. Heliyon 2020, 6, e03624. [Google Scholar] [CrossRef] [PubMed]
- Daoud, A.; Malika, D.; Bakari, S.; Hfaiedh, N.; Mnafgui, K.; Kadri, A.; Gharsallah, N. Assessment of polyphenol composition, antioxidant and antimicrobial properties of various extracts of Date Palm Pollen (DPP) from two Tunisian cultivars. Arab. J. Chem. 2019, 12, 3075–3086. [Google Scholar] [CrossRef]

| Tested Material | Absorption (cm−1) | Appearance | Group | Compound Class |
|---|---|---|---|---|
| GSE | 3754 | Medium, sharp | O-H stretching | Alcohol |
| 3446 | Strong, broad | Dimeric O-H stretch | ||
| 2927 | Strong, broad | Methylene C-H asymmetric | Aliphatic alkene | |
| 1624 | Strong | Skeletal C-C vibrations (methyne) | ||
| 775 | Medium | Alkenyl C=C stretch | Olefinic alkene | |
| 1458 | Medium | C=C-C aromatic ring stretch | Aromatic ring | |
| 1058 | Medium | Aromatic C-H in-plane bend | ||
| GSE-AgNPs | 3276 | Strong, broad | Hydroxy group, H-bonded OH stretch | Alcohol |
| 2204 | Weak | C≡C medial alkyne (disubstituted) | Alkyne | |
| 2161 | Weak | C≡C terminal alkyne (monosubstituted) | ||
| 1992/1966 | Weak | Aromatic combination bands | Aromatic ring | |
| 2043/2022 | Weak | Transition metal carbonyls, cyanide, thiocyanate, or isothiocyanate (-NCS) | Carbonyl or inorganic | |
| 1634 | Medium | Alkenyl C=C stretch | Olefinic alkene |
| Phenolic Compound | Formula | Chemical Structure | Molecular Weight | MS Fragments (m/z) | RI% |
|---|---|---|---|---|---|
| 3-Hydroxyflavone | C15H10O3 | ![]() | 238.242 | 238.25 | 74.80 |
| Anthocyanins | C15H11O+ | ![]() | 207.252 | 207.00 | 47.83 |
| Gallic acid | C7H6O5 | ![]() | 170.12 | 170.00 | 29.81 |
| Cianidanol | C15H14O6 | ![]() | 290.271 | 290.00 | 6.50 |
| Epicatechin gallate | C22H18O10 | ![]() | 442.376 | 442.00 | 1.12 |
| Strains | Control | 10%GSE | 50%GSE | 100%GSE | GSE-AgNPs | AgNO3 | |
|---|---|---|---|---|---|---|---|
| B. subtilis | Mean ± SD | 0.07 ± 0.06 | 0.27 ± 0.21 | 10.5 ± 0.61 | 11 ± 0.44 | 13.5 ± 1 | 0.5 ± 0.1 |
| p-value | 1 | 0.645 | 1.13 × 10−11 * | 7.02 × 10−12 * | 6.13 × 10−13 * | 0.327 | |
| E. coli | Mean ± SD | 0.07 ± 0.12 | 0.2 ± 0.1 | 0.3 ± 0.17 | 0.5 ± 0.1 | 12.5 ± 1 | 0.7 ± 0.1 |
| p-value | 1 | 0.706 | 0.512 | 0.233 | 1.35 × 10−13 * | 0.092 | |
| P. aeruginosa | Mean ± SD | 0.07 ± 0.06 | 0.07 ± 0.06 | 0.5 ± 0.1 | 0.7 ± 0.1 | 13.5 ± 1 | 0.1 ± 0.1 |
| p-value | 1 | 1 | 0.226 | 0.087 | 4.37 × 10−14 * | 0.923 | |
| S. aureus | Mean ± SD | 0.03 ± 0.06 | 0.17 ± 0.16 | 13.5 ± 1.61 | 15 ± 2 | 15 ± 2 | 0.6 ± 0.1 |
| p-value | 1 | 0.904 | 3.37 × 10−8 * | 1.03 × 10−10 * | 1.03 × 10−10 * | 0.612 | |
| Strains | Control | GSE (100%) | GSE-AgNPs (0.2 mL) | AgNO3 (0.2 mL) | |
|---|---|---|---|---|---|
| F. solani | Mean ± SD | 88.23 ± 0.06 | 37.5 ± 0.26 | 17.52 ± 0.03 | 88.15 ± 0.1 |
| p-value | 1 | 9.96 × 10−20 * | 1.21 × 10−37 * | 0.999 | |
| F. oxysporum | Mean ± SD | 88.39 ± 0.15 | 67.5 ± 0.2 | 22.53 ± 0.11 | 88.59 ± 0.11 |
| p-value | 1 | 6.08 × 10−4 * | 1.08 × 10−32 * | 0.957 | |
| A. alternata | Mean ± SD | 88.51 ± 0.11 | 84.91 ± 0.18 | 14.49 ± 0.15 | 88.43 ± 0.09 |
| p-value | 1 | 0.459 | 4.72 × 10−41 * | 0.997 | |
| H. rostratum | Mean ± SD | 88.19 ± 0.07 | 22.75 ± 0.2 | 9.11 ± 0.03 | 88.09 ± 0.13 |
| p-value | 1 | 2.33 × 10−32 * | 6.39 × 10−47 * | 0.991 | |
Publisher’s Note: MDPI stays neutral with regard to jurisdictional claims in published maps and institutional affiliations. |
© 2021 by the authors. Licensee MDPI, Basel, Switzerland. This article is an open access article distributed under the terms and conditions of the Creative Commons Attribution (CC BY) license (https://creativecommons.org/licenses/by/4.0/).
Share and Cite
Al-Otibi, F.; Alkhudhair, S.K.; Alharbi, R.I.; Al-Askar, A.A.; Aljowaie, R.M.; Al-Shehri, S. The Antimicrobial Activities of Silver Nanoparticles from Aqueous Extract of Grape Seeds against Pathogenic Bacteria and Fungi. Molecules 2021, 26, 6081. https://doi.org/10.3390/molecules26196081
Al-Otibi F, Alkhudhair SK, Alharbi RI, Al-Askar AA, Aljowaie RM, Al-Shehri S. The Antimicrobial Activities of Silver Nanoparticles from Aqueous Extract of Grape Seeds against Pathogenic Bacteria and Fungi. Molecules. 2021; 26(19):6081. https://doi.org/10.3390/molecules26196081
Chicago/Turabian StyleAl-Otibi, Fatimah, Shahad K. Alkhudhair, Raedah I. Alharbi, Abdulaziz A. Al-Askar, Reem M. Aljowaie, and Sameha Al-Shehri. 2021. "The Antimicrobial Activities of Silver Nanoparticles from Aqueous Extract of Grape Seeds against Pathogenic Bacteria and Fungi" Molecules 26, no. 19: 6081. https://doi.org/10.3390/molecules26196081
APA StyleAl-Otibi, F., Alkhudhair, S. K., Alharbi, R. I., Al-Askar, A. A., Aljowaie, R. M., & Al-Shehri, S. (2021). The Antimicrobial Activities of Silver Nanoparticles from Aqueous Extract of Grape Seeds against Pathogenic Bacteria and Fungi. Molecules, 26(19), 6081. https://doi.org/10.3390/molecules26196081






